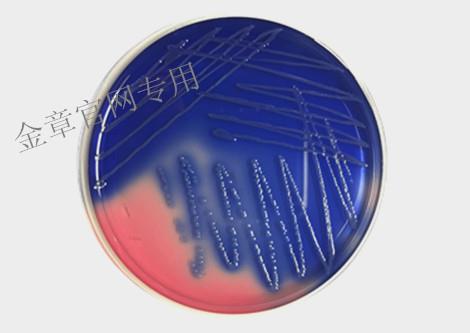

一次性中國藍瓊脂培養(yǎng)基
廣告審查批準文號:津械廣審(文)第260819—03760號
醫(yī)療器械產品技術要求編號:津械注準20172400191
適用范圍:適用于分離培養(yǎng)醫(yī)學常見革蘭陰性細菌。
結構及組成:主要組成成分為中國藍瓊脂混合干粉。
注意事項詳見說明書。
上一個:
一次性麥康凱瓊脂培養(yǎng)基
下一個:
一次性伊紅美藍瓊脂培養(yǎng)基